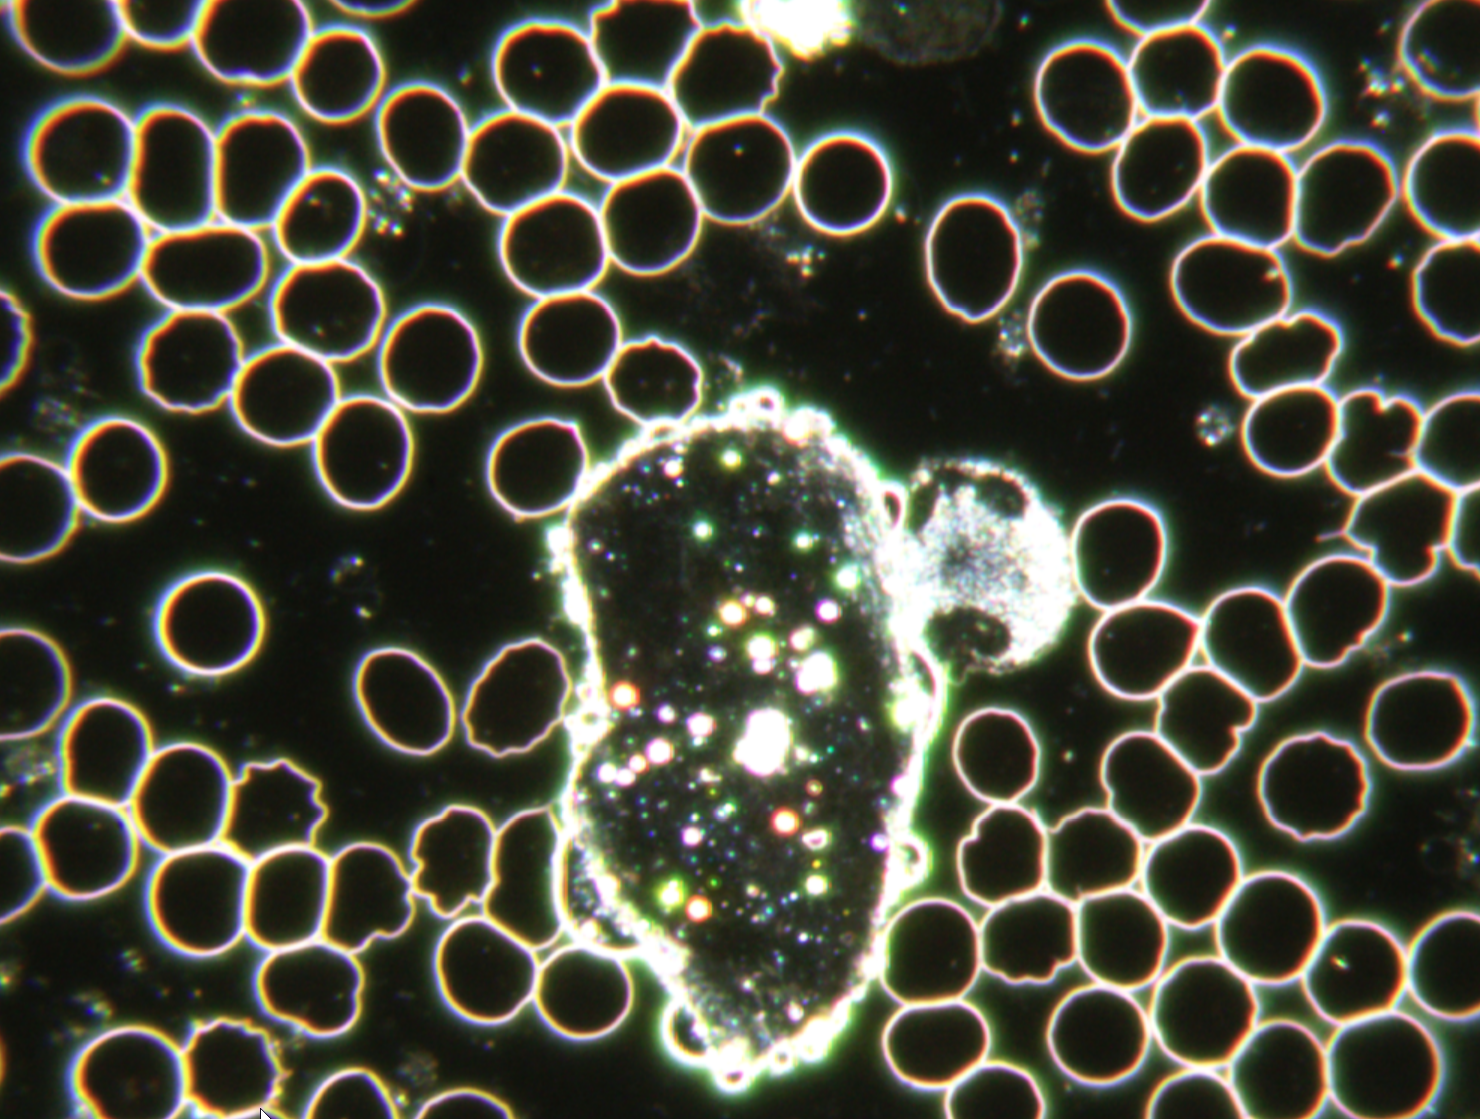
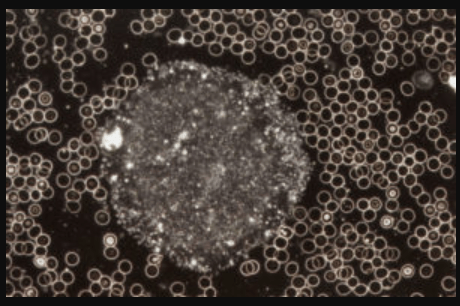
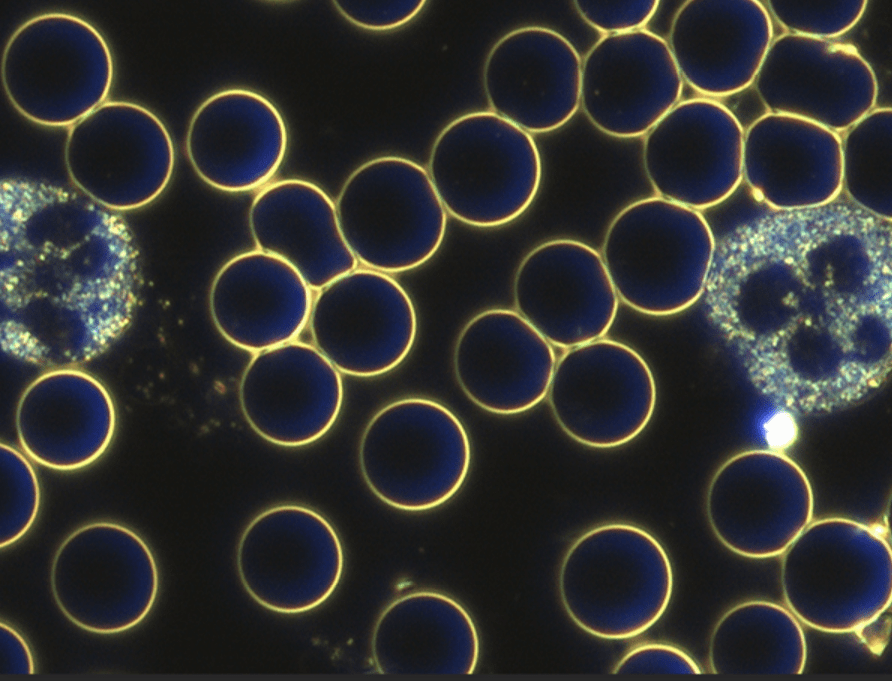

„Das Milieu ist Alles – die Mikrobe ist Nichts“
LOUIS PASTEUR
Manch Einer fragt sich warum werde ich krank und der Andere nicht. Mikroorganismen können sich unter bestimmten Verhältnissen einfach besser entwickeln. Ein gestörtes Körpermilieu ist der beste Nährboden für Erkrankungen. Genau hier setzt diese Untersuchungs- und Behandlungsmethode nach Prof. Dr. Enderlein an. Bei diesem Diagnoseverfahren wird mit Hilfe des Dunkelfeld-Mikroskops ein Tropfen Blut untersucht. Aufgrund der speziellen physikalischen Vorraussetzungen des Dunkelfeld-Mikroskops können Phänomene im Blut erkannt werden und so Rückschlüsse auf Veränderungen im Körpermilieu gezogen werden. Es wird die Anzahl, Form und Beweglichkeit der Weißen und roten Blutkörperchen untersucht, die Lage der Blutblättchen beurteilt und Erscheinungsformen im Plasma bestimmt.
Es können unter anderem Aussagen getroffen werden zu:
- Nährstoff-Mangelerscheinungen
- Oxidative Stressbelastungen
- Fettstoffwechselstörungen
- Durchblutungsstörungen
- Säure-Basen-Haushalt
- Unverträglichkeiten
- Toxinablagerungen
- Immunlagen
- Mikroorganismen
- Mucor- und Aspergilluszykloden
Beispiele:

Darstellung der weißen Blutkörperchen bei Einschränkungen im Immunsystem 
Darstellung von Thrombozytenhaufen als Zeichen einer schlechten Darmschleimhaut 
Darstellung von Symplasten als Zeichen einer Übersäuerung und Erhöhung von oxydativen Stress 
Darstellung von verformten roten Blutkörperchen als Zeichen einer Störung im Fettstoffwechsel 
Darstellung der roten Blutkörperchen bei hoher Schadstoffbelastung 
Darstellung der roten Blutkörperchen mit Zeichen eines Nährstoffmangels in den Zellen 
Darstellung von Geldrollen als Zeichen einer hohen E-Smog Belastung, hohem oxydativen Stress, geringer Trinkmenge 
Darstellung von aufsteigenden Eiweißformen aus den roten Blutkörperchen bei bakterieller und Pilz-Belastung